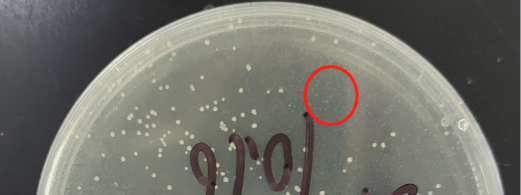

案例分享 | 破解“致命基因”的克隆困局

在合成生物學(xué)的實(shí)驗(yàn)室里,最令人沮喪的時(shí)刻之一,就是你滿懷期待地走向培養(yǎng)箱,卻發(fā)現(xiàn)本應(yīng)長滿菌落的平板上空空如也。這不是實(shí)驗(yàn)的偶然失敗,而是一個(gè)設(shè)計(jì)精妙的“爆破”計(jì)劃,在啟動(dòng)之前就提前泄露了。今天,我們要講述的,就是一個(gè)關(guān)于噬菌體ΦX174中一個(gè)僅有276個(gè)堿基的微小基因——裂解基因E的故事。它不僅是一個(gè)高效的細(xì)菌殺手,更讓我們領(lǐng)悟到,在生命系統(tǒng)的底層,一個(gè)“過于熱心”的助手,是如何讓整個(gè)工程計(jì)劃瀕臨破產(chǎn)的。
一個(gè)小基因,何以100%致死?
噬菌體174E基因編碼的蛋白是一種溶菌酶,具體來說是T4噬菌體溶菌酶。它的作用機(jī)制簡單而粗暴:像一枚精確制導(dǎo)的炸彈,專門靶向細(xì)菌細(xì)胞壁的肽聚糖骨架,水解其中的β-1,4糖苷鍵。
-
作用靶點(diǎn):細(xì)菌的細(xì)胞壁。
-
作用方式:該酶能夠水解細(xì)胞壁肽聚糖中的β-1,4糖苷鍵。肽聚糖是維持細(xì)菌細(xì)胞形狀和結(jié)構(gòu)完整性的關(guān)鍵網(wǎng)絡(luò)結(jié)構(gòu)。
-
最終結(jié)果:一旦細(xì)胞壁被破壞,細(xì)菌細(xì)胞就無法抵抗內(nèi)部的滲透壓。在相對低滲的環(huán)境中,水會大量涌入細(xì)胞,導(dǎo)致細(xì)胞膨脹并最終裂解。這個(gè)過程就像拆掉了水壩的墻體,河水會瞬間沖垮結(jié)構(gòu)一樣。
因此,當(dāng) 174E 基因在細(xì)菌細(xì)胞內(nèi)成功表達(dá)并產(chǎn)生足夠量的溶菌酶時(shí),細(xì)胞裂解是不可避免的,致死率因此是100%。
這正是我們最初想利用它的原因:在需要快速釋放胞內(nèi)蛋白時(shí),或在特定條件下清除含有某種質(zhì)粒的細(xì)菌時(shí),基因E堪稱一把理想的手術(shù)刀。
為何“完美殺手”卻無法被“收編”?
然而,當(dāng)科學(xué)家們嘗試將這把“手術(shù)刀”的藍(lán)圖——基因E,克隆到質(zhì)粒上,并轉(zhuǎn)入大腸桿菌中進(jìn)行保存和擴(kuò)增時(shí),卻遭遇了徹底的失敗。
在常規(guī)的實(shí)驗(yàn)菌株中,克隆的成功率極低,僅有0.4%。平板上幾乎看不到菌落。而那些極少數(shù)的“幸存者”,經(jīng)測序驗(yàn)證,其質(zhì)粒上的基因E往往已經(jīng)發(fā)生了突變,失去了功能。
我們從實(shí)驗(yàn)結(jié)果來看:在質(zhì)粒還未來得及穩(wěn)定復(fù)制和傳代之前,宿主菌就因?yàn)?74E基因的微量表達(dá)而被裂解,導(dǎo)致克隆失敗。在平板上看不到菌落,或者只有極少數(shù)逃逸的菌落。
我們明明還沒有誘導(dǎo)它表達(dá),為什么細(xì)菌還是大批量地死亡?難道這把“手術(shù)刀”在刀鞘里就能殺人嗎?
機(jī)制解析:YES復(fù)合物與SlyD的關(guān)鍵作用
傳統(tǒng)觀點(diǎn)難以解釋為什么在無誘導(dǎo)條件下細(xì)胞仍會裂解。近年來的結(jié)構(gòu)生物學(xué)研究揭示了其核心機(jī)制:YES 三元復(fù)合物的形成。
-
宿主蛋白MraY:宿主細(xì)胞的膜結(jié)合酶,細(xì)胞壁合成的關(guān)鍵節(jié)點(diǎn)。
-
噬菌體蛋白E:噬菌體編碼的裂解效應(yīng)因子。
-
SlyD:宿主編碼的FKBP類肽酰-脯氨酰順反異構(gòu)酶,兼具分子伴侶活性。
SlyD 是裂解機(jī)制的“必要共犯”:在噬菌體的自然感染中,SlyD 并不是一個(gè)需要被繞開的障礙,反而是蛋白E高效行使功能所必需的“分子伴侶”。它通過其伴侶結(jié)構(gòu)域穩(wěn)定地與蛋白E結(jié)合,幫助其精準(zhǔn)地定位并抑制MraY的活性,從而高效地阻斷細(xì)胞壁合成,引發(fā)裂解。
人工構(gòu)建中的“背叛”:
自然感染:噬菌體在準(zhǔn)備好“破壁而出”時(shí),才在特定時(shí)機(jī)表達(dá)蛋白E,并立即利用宿主中已有的SlyD來快速形成YES復(fù)合物,完成裂解。
人工合成:當(dāng)我們把基因E克隆到質(zhì)粒上時(shí),在構(gòu)建過程中,細(xì)菌持續(xù)地、組成型地表達(dá)SlyD(SlyD蛋白在細(xì)菌的整個(gè)生命周期中持續(xù)不斷地被合成)。這意味著,哪怕只有極微量的蛋白E被“泄露表達(dá)”(這是強(qiáng)啟動(dòng)子很難完全避免的),SlyD就會立刻上前“幫忙”,促使形成有功能的YES復(fù)合物,導(dǎo)致細(xì)胞提前裂解。
解決方案:創(chuàng)造一個(gè)“中立區(qū)”
真相大白后,解決方案變得清晰:既然無法阻止基因E的微量泄露,那就移除那個(gè)過于熱心的“助手”。
先敲除 SlyD,實(shí)質(zhì)上是為裂解基因E的質(zhì)粒構(gòu)建創(chuàng)造一個(gè)“無菌、中立”的工作環(huán)境。在這個(gè)環(huán)境里,沒有那個(gè)過于“熱心”且能力強(qiáng)大的助手,基因E可以安全地被組裝、復(fù)制和存儲。而當(dāng)我們真正需要它發(fā)揮作用時(shí)(例如,將質(zhì)粒轉(zhuǎn)入正常的、含有SlyD的致病菌中,或在進(jìn)行誘導(dǎo)表達(dá)時(shí)),它就能完美地執(zhí)行其裂解使命。
-
使用敲除菌,敲除菌成功率100%
-
使用常規(guī)菌,常規(guī)菌成功率0.4%
從困局到工具,廣闊的應(yīng)用場景
理解了這一機(jī)制后,基因E不再是一個(gè)難以駕馭的麻煩,而是變成了一個(gè)極具價(jià)值的精密工具。
高效蛋白純化
在工業(yè)酶或生物制藥蛋白的生產(chǎn)中,將目標(biāo)蛋白與基因E置于同一誘導(dǎo)系統(tǒng)下。表達(dá)結(jié)束后,誘導(dǎo)基因E表達(dá),可以瞬間裂解細(xì)胞,將胞內(nèi)蛋白高效釋放到發(fā)酵液中,極大簡化下游純化工藝,提高收率。
可控的質(zhì)粒消除系統(tǒng)
在復(fù)雜的代謝工程或多質(zhì)粒系統(tǒng)中,需要精確調(diào)控不同基因模塊的存在。可以將基因E置于特定質(zhì)粒上并施加嚴(yán)密調(diào)控。當(dāng)需要將該質(zhì)粒從群體中清除時(shí),只需打開誘導(dǎo)開關(guān),即可特異性殺死含有該質(zhì)粒的細(xì)菌,實(shí)現(xiàn)“編程式”種群凈化。
抗菌新策略的基礎(chǔ)研究
基因E/SlyD系統(tǒng)為開發(fā)新型抗菌劑提供了思路。理論上,可以設(shè)計(jì)能夠干擾MraY-SlyD相互作用的小分子,或構(gòu)建靶向特定病原體的基因回路,實(shí)現(xiàn)精準(zhǔn)的抗菌效果。
>>處理高毒性基因的經(jīng)典范式
ΦX174 基因E的克隆案例,超越了單純的技術(shù)難題解決,它生動(dòng)地闡釋了合成生物學(xué)的一個(gè)核心理念:成功的外源系統(tǒng)重構(gòu),依賴于對宿主內(nèi)在網(wǎng)絡(luò)的深刻理解與工程化改造。
基因E的毒性并非孤立存在,而是通過與宿主因子SlyD形成功能性復(fù)合物得以實(shí)現(xiàn)。通過靶向這一宿主因子,我們成功地將一個(gè)難以駕馭的“殺手”基因,轉(zhuǎn)化為一個(gè)可按需啟用的高效生物工具。
泓迅生物“合成+編輯”整合方案
泓迅生物專注于為客戶提供一站式、定制化的基因合成與編輯解決方案,助力攻克類似的重磅研究難題。
精準(zhǔn)基因編輯服務(wù):憑借先進(jìn)的基因編輯平臺,我們可高效完成包括 SlyD 在內(nèi)的各種基因敲除、點(diǎn)突變及Knock-in,為您量身構(gòu)建理想的工程菌株或細(xì)胞系,為復(fù)雜基因的克隆與功能研究掃清障礙。
高通量基因合成:無論您需要的是像 ΦX174 基因E這樣具有挑戰(zhàn)性的短基因,還是復(fù)雜的長片段,我們都能提供從序列優(yōu)化、寡核苷酸合成到精準(zhǔn)組裝的全流程服務(wù),確保100%的序列準(zhǔn)確度。
“合成+編輯”整合方案:我們尤為擅長將基因合成與宿主工程相結(jié)合,為您提供從“基因藍(lán)圖”到“功能性底盤”的端到端服務(wù),極大加速您的研發(fā)進(jìn)程。
為什么選擇泓迅
領(lǐng)先的技術(shù)優(yōu)勢—AI賦能的合成生物學(xué)技術(shù)

我們可以做—高難度的序列合成

更高的價(jià)值服務(wù)—一站式生物分子解決方案

 Syno?C 引物合成
Syno?C 引物合成 RNA合成
RNA合成 mRNA合成
mRNA合成 Syno?GS 基因合成
Syno?GS 基因合成 載體構(gòu)建
載體構(gòu)建 高通量及DNA文庫構(gòu)建
高通量及DNA文庫構(gòu)建 CRISPR基因編輯平臺
CRISPR基因編輯平臺 病毒包裝
病毒包裝 基因測序及分析
基因測序及分析 重組蛋白表達(dá)平臺
重組蛋白表達(dá)平臺 抗體工程平臺
抗體工程平臺 多肽服務(wù)
多肽服務(wù) 生物信息學(xué)分析與設(shè)計(jì)
生物信息學(xué)分析與設(shè)計(jì) CRISPR文庫
CRISPR文庫 合成生物學(xué)產(chǎn)品
合成生物學(xué)產(chǎn)品 ProXpress蛋白快速檢測
ProXpress蛋白快速檢測 CRISPR 質(zhì)粒
CRISPR 質(zhì)粒





















